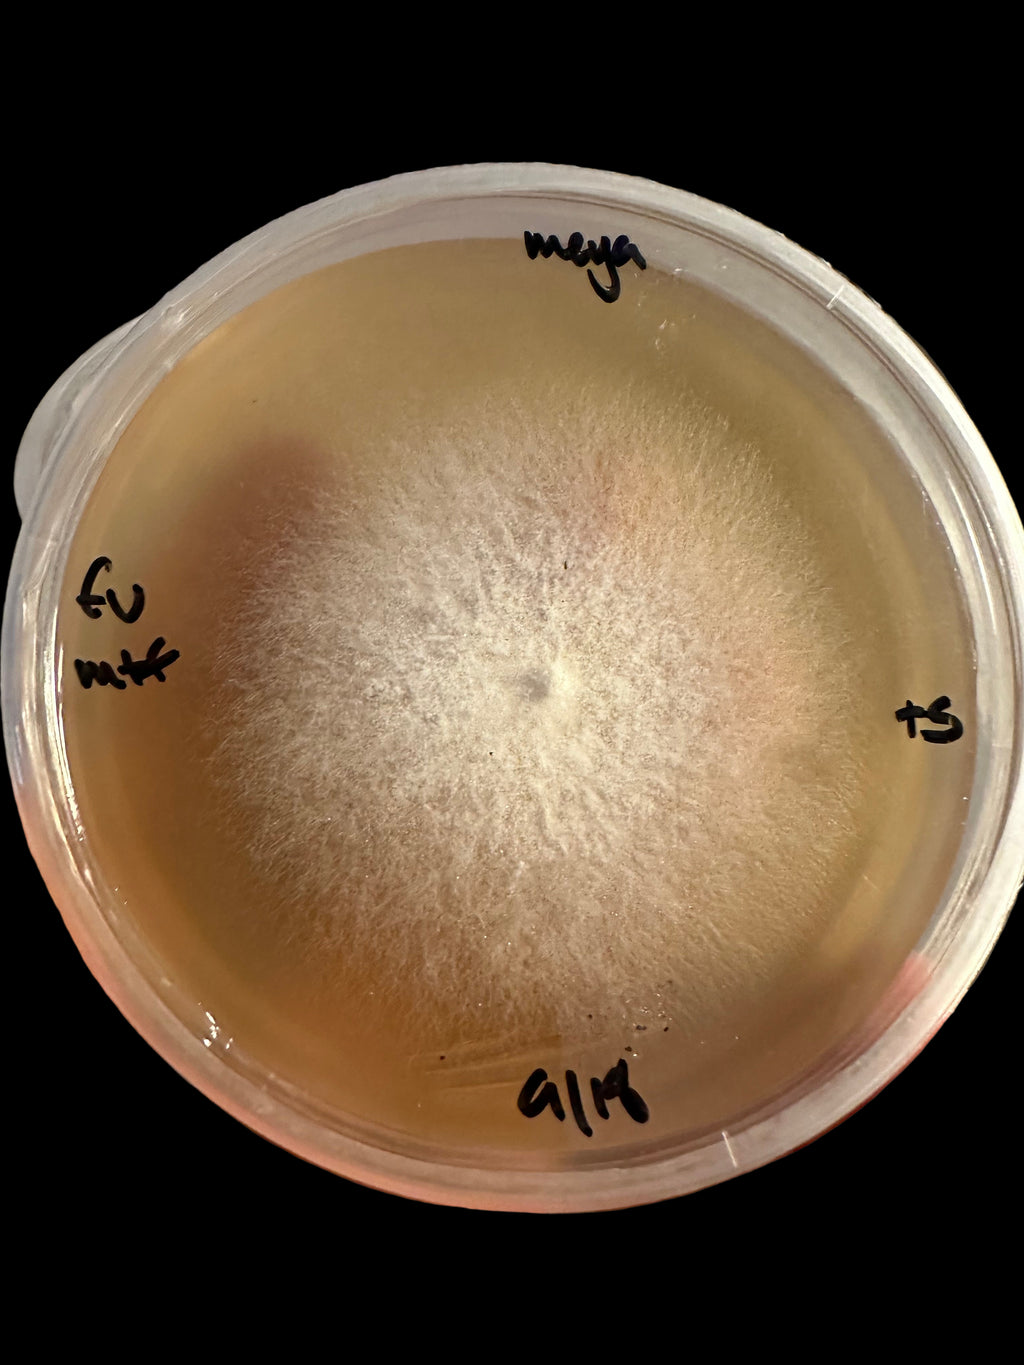
Flammulina velutipes

Skip to product information

Flammulina velutipes
$20.00
Flammulina velutipes, common name velvet shank enoki is a species of mushroom in the family physalacriaceae common to Europe and North America.
This specimen was collected in the forests of New England where they fruit in the early spring and late fall, showing an affinity for elm trees.
They feature an orange cap and stipe, the stipe becoming fuzzy and dark colored velvety with maturity. These are a small to medium sized mushroom, often sticky, or gelatinous, and are saprotrophic favoring dead and dying elm trees. The spore print is white.
These are a choice edible, gourmet mushroom.
Please allow up to four weeks for living culture orders. This is necessary to providing the freshest, cleanest and most vigorous cultures possible!




